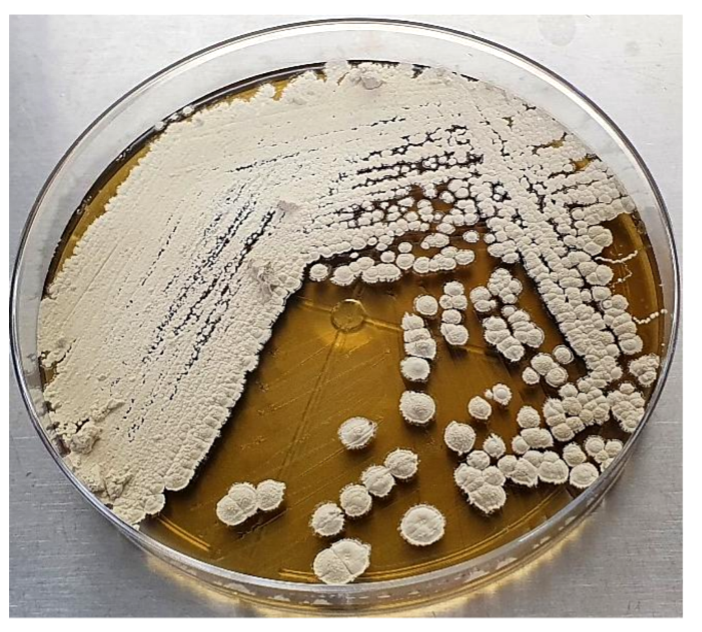
PSL%202019%20Special%20Issue%2008 Macalinao%20et%20al

Philipp. Sci. Lett. 2021 14 (Supplement) 036-046
available online: June 30, 2021
*Corresponding author
Email Address: arcreencia@up.edu.ph
Date received: April 3, 2021
Date revised: June 17, 2021
Date accepted: June 21, 2021
Draft genome sequence of a Philippine mangrove soil actinomycete with insecticidal activity reveals potential as a source of other valuable secondary metabolites
This study was conducted to evaluate the insecticidal activities of 75 Philippine mangrove soil bacterial isolates against the Asian Corn Borer (ACB), Ostrinia furnacalis (Guenée). Through the Contact/Residual method, 20 actinomycetes were found to possess larvicidal activity. Isolate A54 exhibited the strongest activity and was toxic to first-instar ACB larvae using at least 55.02 µg/cm2 crude extract concentration. A 100% larval mortality was achieved from 880.28 to 3,521.13 µg/cm2 concentrations. The LC50 was determined to be 169.82 µg/cm2. Isolate A54 was identified as Streptomyces cavourensis (99.86% similarity) and found to have a G+C content of 72.1%. Whole genome sequencing revealed a genome size of 7,549,018 bp, with 22 contigs, 6,481 predicted genes, 6,395 CDS, 81 tRNA and 4 rRNA. Analysis by antiSMASH identified 31 secondary metabolite biosynthetic gene clusters including those encoding terpene, melanin, ectoine, siderophore, butyrolactone, lanthipeptide, Non-Ribosomal Peptide Synthetase (NRPS) and Polyketide Synthase (PKS). One of the gene cluster products and three of the 162 gene products were revealed to be putative insecticidal compounds. Results indicate that A54 can be used not only as a potential insecticidal product, but also as a possible source of other valuable secondary metabolites which may be used as antioxidants, biomarkers, anti-cancer agents, plant growth-promoters and cosmetic additives.
© 2026 SciEnggJ
Philippine-American Academy of Science and Engineering